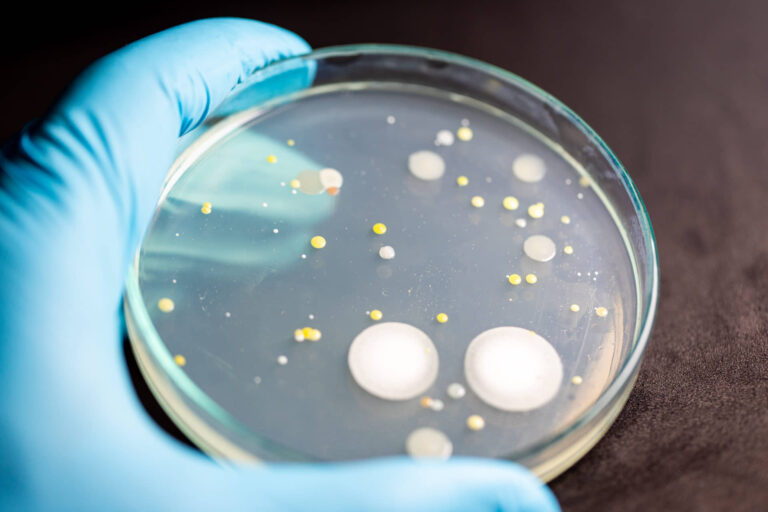
Bacteria in a petri dish

New Jersey's oldest and largest water treatment company.
PFAS: What You Need to Know
Is Your Water Safe?
Tailored Water Solutions for Every Need
Homeowners, Businesses, and Industries
Ready to Improve Your Water Quality?
Why Portasoft of Morris County?
- Industry Expertise and Innovation: At Portasoft, we bring decades of experience and cutting-edge technologies to address the most challenging water quality issues effectively.
- Commitment to Customer Satisfaction: Our success is built on trust and proven results. Dive into our customer testimonials to see how we’ve transformed water systems for countless clients.
- Sustainable and Environmentally-Friendly Solutions: We design systems that reduce environmental impact, promoting efficiency and sustainability in water treatment.

Hear from Our Satisfied Customers
Latest Insights and Resources
Frequently Asked Questions
My system is constantly leaking, what should I do?
If your system is constantly leaking, here’s what you can do:
- Bypass the System: Temporarily bypass it to stop water flow while you troubleshoot.
- Identify the Leak Source: Check valves, seals, and connections for signs of water leakage. Inspect the drain line and fittings for damage or loose connections.
- Inspect Components: Look for worn or damaged seals, O-rings, or fittings. Check for clogs in the drain line.
- Manual Regeneration Test: Run a manual cycle to see if the leak worsens during regeneration.
- Get Professional Help: If you can’t find the issue, visit our support page or contact us for expert assistance.
How Can I Schedule a Consultation with Portasoft?
Scheduling a consultation with Portasoft is simple and convenient. You can book an appointment by visiting our contact page. Alternatively, feel free to call us directly at (973) 584-1549.
Where Is Portasoft of Morris County Located?
Portasoft of Morris County is conveniently located at 578 US HIGHWAY 46, Kenvil, NJ 07847. Our central location enables us to efficiently serve homeowners, commercial clients, and industrial operations throughout the region. We invite you to visit our office for a face-to-face consultation or product demonstration.
What Are Portasoft of Morris County’s Hours of Operation?
Portasoft of Morris County operates from Monday to Friday, between 8:00 AM and 5:00 PM, and on Saturdays from 9:00 AM to 1:00 PM. We are closed on Sundays to ensure our team can rest and recharge. During these hours, our knowledgeable staff is available to assist with consultations, service inquiries, and emergency support.